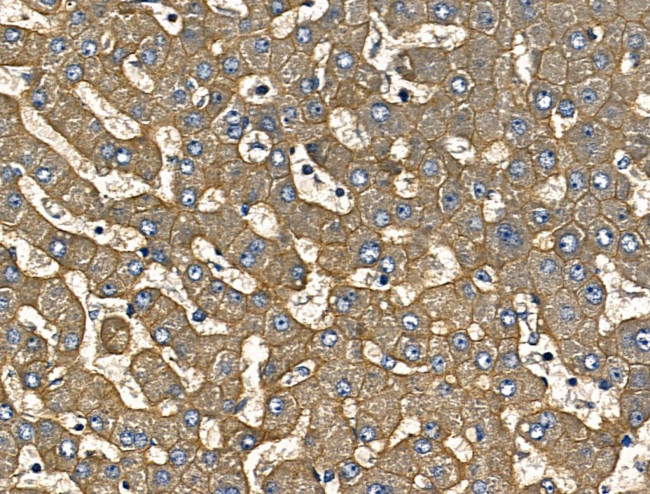
IL-12 p70 Antibody in Immunohistochemistry (Paraffin) (IHC (P))

Search
Invitrogen
IL-12 p70 Polyclonal Antibody
{{$productOrderCtrl.translations['antibody.pdp.commerceCard.promotion.promotions']}}
{{$productOrderCtrl.translations['antibody.pdp.commerceCard.promotion.viewpromo']}}
{{$productOrderCtrl.translations['antibody.pdp.commerceCard.promotion.promocode']}}: {{promo.promoCode}} {{promo.promoTitle}} {{promo.promoDescription}}. {{$productOrderCtrl.translations['antibody.pdp.commerceCard.promotion.learnmore']}}
图: 1 / 4
IL-12 p70 Antibody (PA5-115401) in IHC (P)




Please note: We are reviewing Western blot images included in the antibody testing data in our catalog, including those provided by third parties. Unless expressly labeled or annotated as “raw-unedited”, Western blot images included in the antibody testing data in our catalog may have been edited, optimized or otherwise adjusted for presentation.
产品信息
PA5-115401
种属反应
宿主/亚型
分类
类型
抗原
偶联物
形式
浓度
规格
纯化类型
保存液
内含物
保存条件
运输条件
RRID
产品详细信息
Antibody detects endogenous levels of total IL12A.
靶标信息
IL-12 p70, also known as interleukin-12, is a cytokine that plays a critical role in the immune system's response to infections and cancer. It is produced by immune cells, including dendritic cells, macrophages, and B cells, in response to certain pathogens and tumor cells. IL-12 p70 stimulates the production of interferon-gamma and other cytokines, which promote the activation and proliferation of T cells and natural killer cells. IL-12 p70 has been studied as a potential therapeutic target for various diseases and conditions, including infectious diseases, autoimmune disorders, and cancer. It has been shown to enhance immune responses against certain infections and tumors, and to modulate inflammatory responses in autoimmune diseases.
仅用于科研。不用于诊断过程。未经明确授权不得转售。
篇参考文献 (0)
生物信息学
蛋白别名: 20C2; CLMF p35; CLMF p40; Cytotoxic lymphocyte maturation factor 35 kDa subunit; Cytotoxic lymphocyte maturation factor 40 kDa subunit; il 12; IL 12p70; IL-12 p75; IL-12 subunit p35; IL-12 subunit p40; IL-12A; IL-12B; IL12A/B; IL12AB; ILN; Interleukin; interleukin 12 p35 subunit; interleukin-12 p40; Interleukin-12 p70; Interleukin-12 subunit alpha; Interleukin-12 subunit beta; MGC151228; MGC151232; NK cell stimulatory factor chain 1; NK cell stimulatory factor chain 2; NKSF1; NKSF2
基因别名: Il-12a; Il-12b; IL-12p35; Il-12p40; Il12; IL12A; IL12B; Il12p40; Ll12a; NKSF1; NKSF2; p35; p40
UniProt ID: (Rat) Q9R103, (Mouse) P43431, (Mouse) P43432
Entrez Gene ID: (Rat) 84405, (Mouse) 16159, (Rat) 64546, (Mouse) 16160